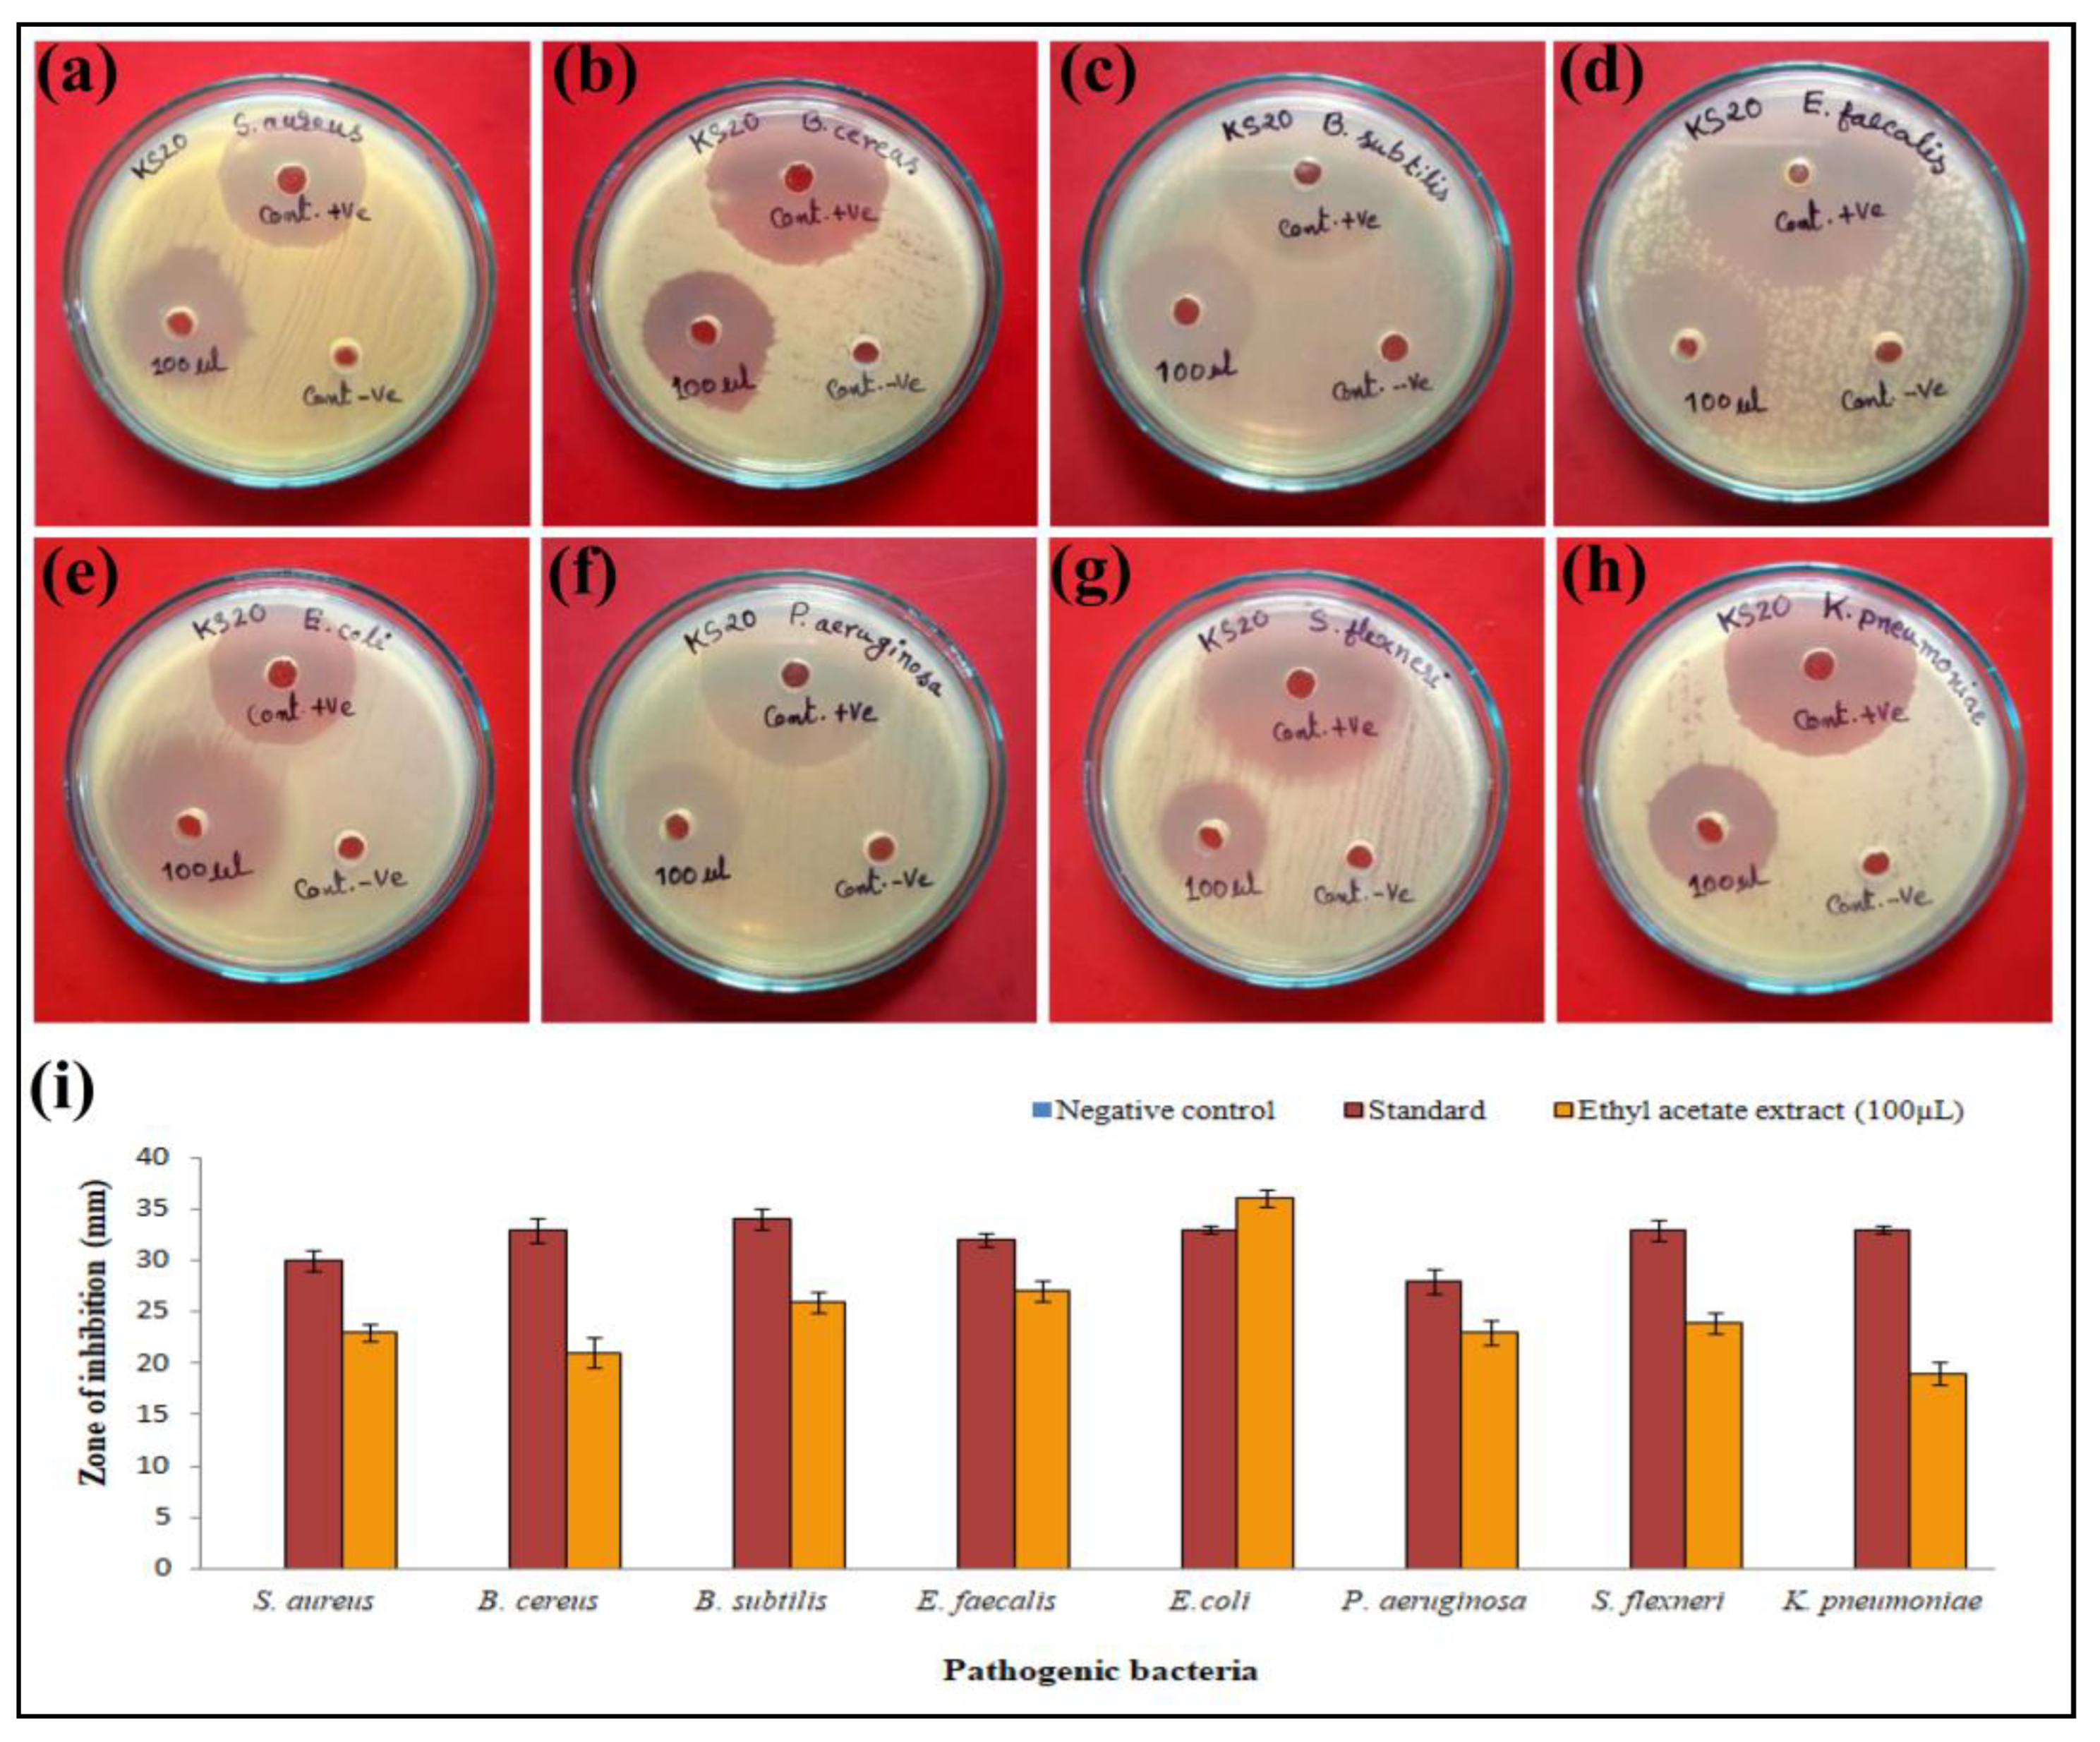
Metabolites 13 01022 g004

Unveiling the Pharmacological Significance of Marine Streptomyces violaceusniger KS20: Isolation, Characterization, and Assessment of Its Biomedical Applications
Abstract
:1. Introduction
2. Materials and Methods
2.1. Pathogens and Materials Used in the Study
2.2. Collection of Samples
2.3. Isolation and Primary Screening
2.4. Polyphasic Taxonomy of Streptomyces sp. KS20
2.4.1. Morphological Characterizations
2.4.2. Molecular Characterization
2.4.3. Physiological Characterizations
2.4.4. Biochemical Characterizations
2.4.5. Production and Extraction of Secondary Metabolites
2.5. Characterizations of Ethyl Acetate Extract
2.5.1. FTIR Spectroscopy
2.5.2. Gas Chromatography–Mass Spectrometry (GC-MS)
2.6. Biological Activities
2.6.1. Antioxidant Activity of Streptomyces sp. KS20 EtOAc-Ex
2.6.2. Antibacterial Activity of Streptomyces sp. KS20 EtOAc-Ex
2.6.3. Assessment of Minimum Inhibitory and Minimum Bactericidal Concentration
2.6.4. Antimycobacterial Activity
2.6.5. Antiproliferative Activity of Streptomyces sp. KS20 EtOAc-Ex
3. Results
3.1. Isolation of Actinomycetes
3.2. Primary Screening of Antimicrobial Activity
3.3. Characterizations of Streptomyces sp. KS20
3.3.1. Morphological Characterizations
3.3.2. Molecular Phylogeny of Streptomyces sp. KS20
3.3.3. Physiological Characterizations
3.3.4. Biochemical Characterizations
3.4. Fermentation and Extraction of Metabolites
3.5. Characterizations of EtOAc-Ex
3.5.1. FTIR Spectroscopy
3.5.2. GC-MS Analysis
3.6. Biological Activities
3.6.1. DPPH Radical-Scavenging Assay of Streptomyces sp. KS20 EtOAc-Ex
3.6.2. Antibacterial Assay of Streptomyces sp. KS20 EtOAc-Ex
3.6.3. Antimycobacterial Activity
3.6.4. Antiproliferative Activity
4. Discussion
5. Conclusions
Author Contributions
Funding
Institutional Review Board Statement
Informed Consent Statement
Data Availability Statement
Acknowledgments
Conflicts of Interest
References
- Galana, S.; Atanas, P.; Ketan, C.; Sathiyaraj, S.; Ramesh, S. Marine actinomycetes associated with stony corals: A potential hotspot for specialized metabolites. Microorganisms 2022, 10, 1349. [Google Scholar]
- Waksman, S.A. Cultural studies of species of actinomyces. Soil Sci. 1919, 8, 71–215. [Google Scholar] [CrossRef]
- Woodruff, H.B. Selman A. Waksman, winner of the 1952 Nobel Prize for physiology or medicine. Appl. Environ. Microbiol. 2014, 80, 2–8. [Google Scholar] [CrossRef]
- Swati, S.; Abhay, B.F.; Asha, C. Bioprospection of marine actinomycetes: Recent advances, challenges and future perspectives. Acta Oceanol. Sin. 2019, 38, 1–17. [Google Scholar]
- Sveta, V.J.; Erika, M.M.; Sarah, E.R.; Maiya, C.C.; William, S. Marine actinomycetes, new sources of biotechnological products. Mar. Drugs. 2021, 19, 365. [Google Scholar]
- Ventura, M.; Canchaya, C.; Tauch, A.; Chandra, G.; Fitzgerald, G.F.; Chater, K.F.; van-Sinderen, D. Genomics of actinobacteria: Tracing the evolutionary history of an ancient phylum. Microbiol. Mol. Biol. Rev. 2007, 71, 495–548. [Google Scholar] [CrossRef]
- Essaid, A.B.; Parul, V.; Lisa, S.; Nathalie, G.V.; Cedric, J.; Klenk, H.P.; Clement, C.; Ouhdouch, Y.; Wezel, G.V. Taxonomy, physiology, and natural products of actinobacteria. Microbiol. Mol. Biol. Rev. 2016, 80, 1–43. [Google Scholar]
- Scott, W.B.; Bailey, B.; Vineetha, M.Z.; Dylan, J.M.; Matthew, F.T. Molecules to ecosystems: Actinomycete natural products in situ. Front. Microbiol. 2017, 7, 2149. [Google Scholar]
- Rashad, F.M.; Fathy, H.M.; Ayatollah, S.Z.; Ahlam, M.E. Isolation and characterization of multifunctional Streptomyces species with antimicrobial, nematicidal and phytohormone activities from marine environments in Egypt. Microbiol. Res. 2015, 175, 34–47. [Google Scholar] [CrossRef]
- Berdy, J. Bioactive microbial metabolites. J. Antibiot. 2005, 58, 1–26. [Google Scholar] [CrossRef]
- Newman, D.J.; Cragg, G.M. Natural products as sources of new drugs over the last 25 years. J. Nat. Prod. 2007, 70, 461–477. [Google Scholar] [CrossRef] [PubMed]
- Olano, C.; Mendez, C.; Salas, J.A. Antitumor compounds from actinomycetes: From gene clusters to new derivatives by combinatorial biosynthesis. Nat. Prod. Rep. 2009, 26, 628–660. [Google Scholar] [CrossRef] [PubMed]
- Ventola, C.L. The antibiotic resistance crisis: Part 1: Causes and threats. Pharm. Ther. 2015, 40, 277–283. [Google Scholar]
- Francesca, P.; Patrizio, P.; Annalisa, P. Antimicrobial resistance: A global multifaceted phenomenon. Pathog. Glob. Health 2015, 109, 309–318. [Google Scholar]
- Aljeldah, M.M. Antimicrobial resistance and its spread is a global threat. Antibiotics 2022, 11, 1082. [Google Scholar] [CrossRef] [PubMed]
- Ramakant, D.; Chandra, M.; Rauthan, A. Evolving trends in lung cancer: Epidemiology, diagnosis, and management. Indian J. Cancer 2022, 59, S90–S105. [Google Scholar]
- Chakraborty, B.; Meghashyama, P.B.; Dhanyakumara, S.B.; Muthuraj, R.; Sreenivasa, N.; Raju, S.K.; Abdulrahman, I.A.; Karthikeyan, P. Biosynthesis and characterization of polysaccharide-capped silver nanoparticles from Acalypha indica L. and evaluation of their biological activities. Environ. Res. 2023, 225, 115614. [Google Scholar] [CrossRef]
- Gebreselema, G.; Feleke, M.; Samuel, S.; Nagappan, R. Isolation and characterization of potential antibiotic producing actinomycetes from water and sediments of Lake Tana, Ethiopia. Asian Pac. J. Trop. Biomed. 2013, 3, 426–435. [Google Scholar]
- Sreenivasa, N.; Chakraborty, B.; Bhat, M.P.; Shashiraj, K.N.; Airodagi, D.; Pallavi, S.S.; Muthuraj, R.; Halaswamy, H.; Dhanyakumara, S.B.; Bharati, K. Biosynthesis, characterization, and in vitro assessment on cytotoxicity of actinomycete-synthesized silver nanoparticles on Allium cepa root tip cells. Beni-Suef Univ. J. Basic Appl. Sci. 2020, 9, 51. [Google Scholar]
- Undabarrena, A.; Beltrametti, F.; Claverias, F.P.; Gonzalez, M.; Moore, E.R.B.; Seeger, M.; Camara, B. Exploring the diversity and antimicrobial potential of marine actinobacteria from the Comau Fjord in Northern Patagonia, Chile. Front. Microbiol. 2016, 7, 1135. [Google Scholar] [CrossRef]
- Divya, P.; Nawani, N.N. A rapid and improved technique for scanning electron microscopy of actinomycetes. J. Microbiol. Methods 2014, 99, 54–57. [Google Scholar]
- Hamid, M.E.; Adil, M.; Abdulrhman, J.B.; Hussein, A.B.; Holie, A.M.; Mogahid, M.E.; Martin, R.J. Isolation and identification of Streptomyces spp. from desert and Savanna soils in Sudan. Int. J. Environ. Res. Public Health 2020, 17, 8749. [Google Scholar] [CrossRef] [PubMed]
- Firew, E.; Sudhamani, M.; Diriba, M.; Belachew, T. Antimicrobial potential of Streptomyces spp. isolated from the Rift valley regions of Ethiopia. Adv. Pharmacol. Pharm. Sci. 2022, 2022, 1724906. [Google Scholar]
- Bidhayak, C.; Raju, S.K.; Abdulrahman, I.A.; Karthikeyan, P.; Sreenivasa, N.; Kathirvel, B. Streptomyces filamentosus strain KS17 isolated from microbiologically unexplored marine ecosystems exhibited a broad spectrum of antimicrobial activity against human pathogens. Process Biochem. 2022, 117, 42–52. [Google Scholar]
- Shiv, N.S.; Ramesh, M.; Sunil, R.; Arjun, G.; Bhageshwor, B.; Lalu, P.Y.; Ranjit, K.S.; Pradeep, K.S. Fermentation and extraction of antibacterial metabolite using Streptomyces spp. isolated from Taplejung, Nepal. J. Inst. Sci. Technol. 2021, 26, 8–15. [Google Scholar]
- Adeyemo, O.M.; Jaafaru, M.I.; Adams, F.V. Isolation, characterization, antimicrobial and other bioactivity profiles of three Streptomyces strains isolated from Lake Gerio, Yola, Adamawa State, Nigeria. Bull. Natl. Res. Cent. 2021, 45, 147. [Google Scholar] [CrossRef]
- Moaz, M.H.; Lamis, S.A.; Nayer, M.F. Antimicrobial activity of marine actinomycetes and the optimization of culture conditions for the production of antimicrobial agent(s). J. Pure Appl. Microbiol. 2019, 13, 2177–2188. [Google Scholar]
- Janpen, T.; Pluempanupat, W.; Rungnapa, T.; Waraporn, Y.; Roongtawan, S. Antibacterial, antioxidant, cytotoxic effects and GC-MS analysis of mangrove derived Streptomyces achromogenes TCH4 extract. Arch. Biol. Sci. 2021, 73, 223–235. [Google Scholar]
- Nayer, M.F.; Asmaa, M.T. Isolation and characterization of marine sponge associated Streptomyces sp. NMF6 strain producing secondary metabolite(s) possessing antimicrobial, antioxidant, anticancer, and antiviral activities. J. Genet. Eng. Biotechnol. 2021, 19, 102. [Google Scholar]
- Elshikh, M.; Syed, A.; Scott, F.; Paul, D.; Mark, M.G.; Roger, M.; Ibrahim, M.B. Resazurin-based 96-well plate microdilution method for the determination of minimum inhibitory concentration of biosurfactants. Biotechnol. Lett. 2016, 38, 1015–1019. [Google Scholar] [CrossRef]
- Ramaiah, M.; Devilal, K.; Satish, B.; Harika, P. In-vitro MABA anti-tuberculosis assay of Eclipta alba (L.) Hassk whole plant. Pharm. Innov. J. 2017, 6, 103–105. [Google Scholar]
- Marcelo, M.P.T.; Luciana, C.F.; Vida, M.B.L.; Anelize, B.; Karen, V.A.; Paula, C.J.; Leandro, M.G.; Gabriel, P.; Norberto, P.L.; Leticia, V.C.L.; et al. Metabolomic study of marine Streptomyces sp.: Secondary metabolites and the production of potential anticancer compounds. PLoS ONE 2020, 15, e0244385. [Google Scholar]
- Sivakumar, R.; Jebanesan, A.; Govindarajan, M.; Rajasekar, P. Larvicidal and repellent activity of tetradecanoic acid against Aedes aegypti (Linn.) and Culex quinquefasciatus (Say.) (Diptera: Culicidae). Asian Pac. J. Trop. Med. 2011, 4, 706–710. [Google Scholar] [CrossRef] [PubMed]
- Venn-Watson, S.; Lumpkin, R.; Dennis, E.A. Efficacy of dietary odd-chain saturated fatty acid pentadecanoic acid parallels broad associated health benefits in humans: Could it be essential? Sci. Rep. 2020, 10, 8161. [Google Scholar] [CrossRef] [PubMed]
- Eman, A.E.; Sanaa, M.M.S.; Hanan, S.G.; Tantawy, A.M.; Emad, A.S. Evaluation of antioxidant and anticancer activity of crude extract and different fractions of Chlorella vulgaris axenic culture grown under various concentrations of copper ions. BMC Complement Med. Ther. 2021, 21, 51. [Google Scholar]
- Mathavi, P.; Nethaji, S. Velavan GC-MS analysis of phytocomponents in the methanolic extract of Shorea robusta. Int. J. Sci. Res. 2015, 4, 1935–1938. [Google Scholar]
- Priyanka, G.; Bunty, K.D.; Neelam, B.; Navneet, S.C. Comparative GC-MS analysis of bioactive phytochemicals from different plant parts and callus of Leptadenia reticulate Wight and Arn. Pharmacogn. J. 2019, 11, 129–140. [Google Scholar]
- Faridha, B.I.; Mohankumar, R.; Jeevan, M.; Ramani, K. GC-MS analysis of bio-active molecules derived from Paracoccus pantotrophus FMR19 and the antimicrobial activity against bacterial pathogens and MDROs. Indian J. Microbiol. 2016, 56, 426–432. [Google Scholar] [CrossRef]
- Sabri, N.E.; Khalilah, B.; Dzulfadli, R.; Shamala, S.; Mohd, S.H.; Roshada, H. Solvents extraction effects on bioactive compounds of Ajwa date (Phoenix dactylifera L.) flesh using mixture design. Chem. Eng. Trans. 2018, 63, 817–822. [Google Scholar]
- Ramya, K.S.; Kanimathi, P.; Radha, A. GC-MS analysis and antimicrobial activity of various solvent extracts from Simarouba glauca leaves. J. Pharmacogn. Phytochem. 2019, 8, 166–171. [Google Scholar]
- Vambe, M.; Aremu, A.O.; Chukwujekwu, J.C.; Gruz, J.; Luterova, A.; Finnie, J.F.; Van-Staden, J. Antibacterial, mutagenic properties and chemical characterisation of sugar bush (Protea caffra Meisn.): A south african native shrub species. Plants 2020, 9, 1331. [Google Scholar] [CrossRef] [PubMed]
- Mahendrarajan, V.; Pitchaipillai, S.G.; Renganathan, S.; Jeyachandran, A.; Arumugam, V.R.; Kulanthaivel, L.; Jamuna, V.; Samuthira, N.; Kaliaperumal, R.; Esaki, M.S. Inhibition of quorum sensing and biofilm formation in Chromobacterium violaceum by fruit extracts of Passiflora edulis. ACS Omega 2020, 5, 25605–25616. [Google Scholar]
- Sundarapandian, S.; Junaid, M.H.D.; Sathish, K.K.; Saravanan, M.; Kantha, D.A. Effect of solvent on the phytochemical extraction and GC-MS analysis of Gymnema sylvestre. Pharmacogn. J. 2020, 12, 749–761. [Google Scholar]
- Bensaad, M.S.; Dassamiour, S.; Hambaba, L.; Kahoul, M.A.; Sami, R.; Masoudi, L.M.; Mushhin, A.A.; Benajiba, N. Chemical profile by gas chromatography/mass spectrometry of ethyl acetate and N-butanol extracts of Centaurea tougourensis Boiss. & Reut. J. Biobased. Mater. Bioenergy 2022, 16, 140–149. [Google Scholar]
- Sengupta, S.; Pramanik, A.; Ghosh, A.; Bhattacharyya, M. Antimicrobial activities of actinomycetes isolated from unexplored regions of Sundarbans mangrove ecosystem. BMC Microbiol. 2015, 15, 170. [Google Scholar] [CrossRef]
- Mounyr, B.; Moulay, S.; Saad, K.I. Methods for in vitro evaluating antimicrobial activity: A review. J. Pharm. Anal. 2016, 6, 71–79. [Google Scholar]
- Nayaka, S.; Muthuraj, R.; Bidhayak, C.; Meghashyama, P.B.; Pallavi, S.S.; Shashiraj, K.N.; Halaswamy, H.M.; Dhanyakumara, S.B.; Dattatraya, A.; Kavitha, H. A potential bioactive secondary metabolites and antimicrobial efficacy of Streptomyces thermocarboxydus strain KSA-2, isolated from Kali River, Karwar. Curr. Res. Microbiol. Infect. 2020, 1, 5–13. [Google Scholar] [CrossRef]
- Shuangqing, Z.; Xiaobo, Y.; Dongyi, H.; Xiaolong, H. Streptomyces solisilvae sp. nov., isolated from tropical forest soil. Int. J. Syst. Evol. Microbiol. 2017, 67, 3553–3558. [Google Scholar]
- Cox, M.J.; Cookson, W.O.; Moffatt, M.F. Sequencing the human microbiome in health and disease. Hum. Mol. Genet. 2013, 22, 88–94. [Google Scholar] [CrossRef]
- Sreenivasa, N.; Chethan, J.D.; Girish, B.K.; Ravichandra, H.; Pallavi, S.S.; Bidhayak, C. Molecular characterization and antimicrobial efficacy of Streptomyces gancidicus strain SN-3 from soil samples. J. Microbiol. Res. 2018, 8, 97–102. [Google Scholar]
- Varsha, S.; Padmanabhan, P.; Sriparna, S. Evaluations of the VITEK 2 BCL card for identification of biosurfactant producing bacterial isolate SPS1001. In Biotechnology and Biological Sciences; Ramkrishna, S., Mukherjee, S., Paul, R., Narula, R., Eds.; Taylor & Francis Group: London, UK, 2020; pp. 315–319. [Google Scholar]
- Meghashyama, P.B.; Sreenivasa, N.; Raju, S.K. A swamp forest Streptomyces sp. strain KF15 with broad spectrum antifungal activity against chilli pathogens exhibits anticancer activity on HeLa cells. Arch. Microbiol. 2022, 204, 540. [Google Scholar]
- Othman, N. IR spectroscopy in qualitative and quantitative analysis. In Infrared Spectroscopy; El-Azazy, M., Al-Saad, K., El-Shafie, A.S., Eds.; IntechOpen: London, UK, 2023; pp. 1–16. [Google Scholar]
- Chakraborty, B.; Raju, S.K.; Abdulrahman, I.A.; Pethaiah, G.; Sreenivasa, N. Bioprospection and secondary metabolites profiling of marine Streptomyces levis strain KS46. Saud. J. Biol. Sci. 2022, 29, 667–679. [Google Scholar] [CrossRef] [PubMed]
- Chakraborty, B.; Raju, S.K.; Abdulrahman, I.A.; Kotresha, D.; Muthuraj, R.; Pallavi, S.S.; Halaswamy, H.; Karthikeyan, P.; Sreenivasa, N. Evaluation of antioxidant, antimicrobial and antiproliferative activity of silver nanoparticles derived from Galphimia glauca leaf extract. J. King Saud Univ. Sci. 2021, 33, 101660. [Google Scholar] [CrossRef]
- Wageeh, A.Y.; Noorsaadah, A.R.; Azhar, A.; Sharifah, B.A.H.; Abeer, A.A.; Farkaad, A.K.; Marzieh, Y. Understanding the chemistry behind the antioxidant activities of butylated hydroxytoluene (BHT): A review. Eur. J. Med. Chem. 2015, 101, 295e312. [Google Scholar]
- Nur, A.M.; Nusrat, J.B.; Rafiquzzaman, M. Review on in-vivo and in-vitro methods evaluation of antioxidant activity. Saudi Pharm. J. 2013, 21, 143–152. [Google Scholar]
- Dharaneedharan, S.; Min, S.K.; Dong, H.K.; Moon, S.H. Isolation, characterization, antioxidant, antimicrobial and cytotoxic affects of marine actinomycete, Streptomyces carpaticus MK-01, against fish pathogens. Braz. Arch. Biol. Technol. 2017, 60, e170539. [Google Scholar]
- Natalia, V.; Elisavet, S.; Chrysa, V.; Christina, T.; Eugenia, B. Towards advances in medicinal plant antimicrobial activity: A review study on challenges and future perspectives. Microorganisms 2021, 9, 2041. [Google Scholar]
- Patrick, F.M.; Robert, D.W.; David, G.W. Antimicrobials: Modes of Action and Mechanisms of Resistance. Int. J. Toxicol. 2003, 22, 135–143. [Google Scholar]
- Bahman, K.; Milad, I.; Vahid, S.; Bibi, S.F.B. Review on plant antimicrobials: A mechanistic viewpoint. Antimicrob. Resist. Infect. Control 2019, 8, 118. [Google Scholar]
- Sahra, K.; Nesrin, G.; Bekir, S.K. The action mechanisms of antibiotics and antibiotic resistance. In Antimicrobials, Antibiotic Resistance, Antibiofilm Strategies and Activity Methods; Sahra, K., Ed.; IntechOpen: London, UK, 2019; pp. 1–9. [Google Scholar]
- Joshi, S.; Yadav, D.; Yadav, R. Fluoroquinolones: A review on anti-tubercular activity. Monatsh. Chem. 2021, 152, 881–894. [Google Scholar] [CrossRef]
- Anuradha, S.; Kumar, K.S.; Bhama, S.; Kishan, V. Fermentation, isolation, purification and characterization of an antitubercular antibiotic from Streptomyces luridus MTCC 4402. Indian J. Exp. Biol. 2016, 54, 577–585. [Google Scholar]
- Renu, S.; Monisha, K.; Rup, L. Bioactive compounds from marine actinomycetes. Indian J. Microbiol. 2008, 48, 410–431. [Google Scholar]
- La-ongthong, V.; Suwanna, K. Cytotoxicity evaluation of a Thai herb using tetrazolium (MTT) and sulforhodamine B (SRB) assays. J. Anal. Sci. Technol. 2018, 9, 15. [Google Scholar]
- Thazin, N.A.; Zhipeng, Q.; Daniel, R.K.; David, L.A. Understanding the effectiveness of natural compound mixtures in cancer through their molecular mode of action. Int. J. Mol. Sci. 2017, 18, 656. [Google Scholar]
- Nagaraja, S.K.; Niazi, S.K.; Bepari, A.; Assiri, R.A.; Nayaka, S. Leonotis nepetifolia flower bud extract mediated green synthesis of silver nanoparticles, their characterization, and In vitro evaluation of biological applications. Materials 2022, 15, 8990. [Google Scholar] [CrossRef]
- Bhat, P.M.; Bidhayak, C.; Shashiraj, K.N.; Pooja, V.G.; Raju, S.K.; Sreenivasa, N.; Abdulrahman, I.A.; Karthikeyan, P. Aspergillus niger CJ6 extract with antimicrobial potential promotes in-vitro cytotoxicity and induced apoptosis against MIA PaCa-2 cell line. Environ. Res. 2023, 229, 116008. [Google Scholar] [CrossRef]
- Balachandran, C.; Duraipandiyan, V.; Valan, A.M.; Ignacimuthu, S. Antimicrobial, antioxidant and cytotoxic properties of Streptomyces sp. (Erinlg-01) isolated from Southern Western Ghats. Int. J. Pharm. Pharm. Sci. 2013, 6, 189–196. [Google Scholar]

| Growth in Different NaCl Concentrations | Growth at Different pH | Growth at Different Temperatures | |||
|---|---|---|---|---|---|
| Tests | Results | Tests | Results | Tests | Results |
| 1% | − | pH 5.0 | − | 20 °C | − |
| 2% | w | pH 6.0 | + | 25 °C | w |
| 3% | ++ | pH 7.0 | ++ | 30 °C | ++ |
| 4% | ++ | pH 8.0 | w | 35 °C | w |
| 5% | ++ | pH 9.0 | − | 40 °C | − |
| 6% | w | pH 10.0 | − | 45 °C | − |
| 7% | − | ||||
| Tests | Amount per Well (mg) | Results | Tests | Amount per Well (mg) | Results |
|---|---|---|---|---|---|
| BETA-XYLOSIDASE | 0.0324 | − | D-MANNITOL | 0.3 | − |
| L-Lysine-ARYLAMIDASE | 0.0228 | + | D-MANNOSE | 0.3 | + |
| L-Aspartate ARYLAMIDASE | 40.024 | + | D-MELEZITOSE | 0.3 | − |
| Leucine ARYLAMIDASE | 0.0234 | + | N-ACETYL-D-GLUCOSAMINE | 0.3 | − |
| Phenylalanine ARYLAMIDASE | 0.0264 | + | PALATINOSE | 0.3 | − |
| L-Proline ARYLAMIDASE | 0.0234 | + | L-RHAMNOSE | 0.3 | − |
| BETA-GALACTOSIDASE | 0.036 | + | BETA-GLUCOSIDASE | 0.036 | + |
| L-Pyrrolidonyl-ARYLAMIDASE | 0.018 | − | BETA-MANNOSIDASE | 0.036 | − |
| ALPHA-GALACTOSIDASE | 0.036 | + | PHOSPHORYL CHOLINE | 0.0366 | + |
| Alanine ARYLAMIDASE | 0.0222 | + | PYRUVATE | 0.15 | − |
| Tyrosine ARYLAMIDASE | 0.0282 | + | ALPHA-GLUCOSIDASE | 0.036 | + |
| BETA-N-ACETYL-GLUCOSAMINIDASE | 0.0408 | + | D-TAGATOSE | 0.3 | − |
| Ala-Phe-Pro ARYLAMIDASE | 0.0384 | + | D-TREHALOSE | 0.3 | − |
| CYCLODEXTRIN | 0.3 | + | INULIN | 0.12 | − |
| D-GALACTOSE | 0.3 | − | D-GLUCOSE | 0.3 | − |
| GLYCOGEN | 0.1875 | − | D-RIBOSE | 0.3 | − |
| myo-INOSITOL | 0.3 | − | PUTRESCINE assimilation | 0.201 | − |
| METHYL-A-D-GLUCOPYRANOSIDE acidification | 0.3 | − | GROWTH IN 6.5% NaCl | 1.95 | − |
| ELLMAN | 0.03 | − | KANAMYCIN RESISTANCE | 0.006 | − |
| METHYL-D-XYLOSIDE | 0.3 | − | OLEANDOMYCIN RESISTANCE | 0.003 | − |
| ALPHA-MANNOSIDASE | 0.036 | + | ESCULIN hydrolysis | 0.0225 | + |
| MALTOTRIOSE | 0.3 | − | TETRAZOLIUM RED | 0.0189 | + |
| Glycine ARYLAMIDASE | 0.012 | + | POLYMIXIN_B RESISTANCE | 0.00093 | − |
| Compound Names | Retention Times | Area% | Chemical Formulas | Molecular Weights | Biological Activities | References |
|---|---|---|---|---|---|---|
| Trans-8-Methyl-1.beta.-acetyl-hydrindan | 23.158 | 1.35 | C12H20O | 180.29 | - | - |
| Tetradecanoic acid | 24.666 | 1.26 | C14H28O2 | 228.3 | Nematicidal, antibacterial, and larvicidal | [33] |
| Pentadecanoic acid | 25.618 | 1.70 | C15H30O2 | 242.40 | Anti-inflammatory, anticancer antifibrotic, red blood cell stabilizer | [34] |
| 1,7-Dimethyl-4-(1-methylethyl)cyclodecane | 26.009 | 1.30 | C15H30 | 210.40 | - | - |
| Heptadecanal | 26.837 | 0.94 | C17H34O | 254.5 | - | - |
| 7,9-Di-tert-butyl-1-oxaspiro[4.5]deca-6,9-diene-2,8-dione | 26.903 | 3.35 | C17H24O3 | 276.4 | Antioxidant, antimicrobial | [35] |
| L-(+)-Ascorbic acid 2,6-dihexadecanoate | 27.555 | 5.84 | C38H68O8 | 652.9 | Antioxidant, antibacterial, antiviral, antiscorbutic, anti-inflammatory, anticancer, antimutagenic | [36,37] |
| Fumaric acid, isopropyl tetradecyl ester | 28.309 | 1.34 | C21H38O4 | 354.5 | - | - |
| Hexadecane-1,2-diol | 28.704 | 1.20 | C16H34O2 | 258.44 | - | - |
| n-Nonadecanol-1 | 28.947 | 27.66 | C19H40O | 284.5 | Antimicrobial, anticancer | [38] |
| Nonadecyl pentafluoropropionate | 30.142 | 2.49 | C22H39F5O2 | 430.5 | Antioxidant | [39] |
| Octacosyl acetate | 30.310 | 2.91 | C30H60O2 | 452.8 | - | - |
| Heptacosyl acetate | 30.949 | 0.81 | C29H58O2 | 438.8 | - | - |
| Triarachine | 31.192 | 1.82 | C63H122O6 | 975.63 | Plays an important role in metabolism as energy source | [40] |
| 1-Heptacosanol | 32.089 | 1.64 | C27H56O | 396.73 | Antimicrobial, antidiabetic, antioxidant, nematocidal | [41] |
| Methyl 5(Z),11(Z),14(Z)-Eicosatrienoate | 32.785 | 0.54 | C21H36O2 | 320.51 | - | - |
| cis-1-Chloro-9-octadecene | 32.836 | 1.29 | C18H35Cl | 286.9 | - | - |
| Hexadecanoic acid, 2-hydroxy-1-(hydroxymethyl)ethyl ester | 33.125 | 1.96 | C19H38O4 | 330.50 | Antimicrobial, antioxidant, pesticide, hemolytic | [42] |
| Docosyl ethyl carbonate | 33.307 | 2.37 | C25H50O3 | 398.66 | - | |
| Phthalic acid, di(2-propylpentyl) ester | 33.450 | 1.50 | C24H38O4 | 390.55 | Anticancer | [43] |
| Tetrapentacontane, 1,54-dibromo- | 34.588 | 1.20 | C54H108Br2 | 917.2 | Can treat chronic illnesses | [44] |
| 3-Ethyl-3-methylnonadecane | 36.797 | 1.24 | C22H46 | 310.6 | - | - |
| Stigmast-5-en-3-ol, oleate | 37.965 | 1.30 | C47H82O2 | 679.2 | - | - |
| Zone of Inhibition (mm) | ||||
|---|---|---|---|---|
| Including 6 mm Well Diameter | Excluding 6 mm Well Diameter | |||
| Pathogens | Standard | EtOAc-Ex | Standard | EtOAc-Ex |
| S. aureus | 30 ± 0.93 | 23 ± 0.83 | 24 ± 0.93 | 17 ± 0.83 |
| B. cereus | 33 ± 1.24 | 21 ± 1.46 | 27 ± 1.24 | 15 ± 1.46 |
| B. subtilis | 34 ± 0.98 | 26 ± 1.05 | 28 ± 0.98 | 20 ± 1.05 |
| E. faecalis | 32 ± 0.69 | 27 ± 1.01 | 26 ± 0.69 | 21 ± 1.01 |
| E. coli | 33 ± 0.36 | 36 ± 0.83 | 27 ± 0.36 | 30 ± 0.83 |
| P. aeruginosa | 28 ± 1.25 | 23 ± 1.16 | 22 ± 1.25 | 17 ± 1.16 |
| S. flexneri | 33 ± 0.97 | 24 ± 1.16 | 27 ± 0.97 | 18 ± 1.16 |
| K. pneumoniae | 33 ± 0.39 | 19 ± 1.14 | 27 ± 0.39 | 13 ± 1.14 |
| Broth Dilution Assay | ||
|---|---|---|
| Pathogens | MIC (µg/mL) | MBC (µg/mL) |
| S. aureus | 3.12 | 6.25 |
| B. cereus | 6.25 | 12.5 |
| B. subtilis | 3.12 | 3.12 |
| E. faecalis | 3.12 | 6.25 |
| E. coli | 12.5 | 25 |
| P. aeruginosa | 12.5 | 25 |
| S. flexneri | 3.12 | 6.25 |
| K. pneumoniae | 12.5 | 25 |
Disclaimer/Publisher’s Note: The statements, opinions and data contained in all publications are solely those of the individual author(s) and contributor(s) and not of MDPI and/or the editor(s). MDPI and/or the editor(s) disclaim responsibility for any injury to people or property resulting from any ideas, methods, instructions or products referred to in the content. |
© 2023 by the authors. Licensee MDPI, Basel, Switzerland. This article is an open access article distributed under the terms and conditions of the Creative Commons Attribution (CC BY) license (https://creativecommons.org/licenses/by/4.0/).
Share and Cite
Chakraborty, B.; Shashiraj, K.N.; Kumar, R.S.; Bhat, M.P.; Basavarajappa, D.S.; Almansour, A.I.; Perumal, K.; Nayaka, S. Unveiling the Pharmacological Significance of Marine Streptomyces violaceusniger KS20: Isolation, Characterization, and Assessment of Its Biomedical Applications. Metabolites 2023, 13, 1022. https://doi.org/10.3390/metabo13091022
Chakraborty B, Shashiraj KN, Kumar RS, Bhat MP, Basavarajappa DS, Almansour AI, Perumal K, Nayaka S. Unveiling the Pharmacological Significance of Marine Streptomyces violaceusniger KS20: Isolation, Characterization, and Assessment of Its Biomedical Applications. Metabolites. 2023; 13(9):1022. https://doi.org/10.3390/metabo13091022
Chicago/Turabian StyleChakraborty, Bidhayak, Kariyellappa Nagaraja Shashiraj, Raju Suresh Kumar, Meghashyama Prabhakara Bhat, Dhanyakumara Shivapoojar Basavarajappa, Abdulrahman I. Almansour, Karthikeyan Perumal, and Sreenivasa Nayaka. 2023. "Unveiling the Pharmacological Significance of Marine Streptomyces violaceusniger KS20: Isolation, Characterization, and Assessment of Its Biomedical Applications" Metabolites 13, no. 9: 1022. https://doi.org/10.3390/metabo13091022
APA StyleChakraborty, B., Shashiraj, K. N., Kumar, R. S., Bhat, M. P., Basavarajappa, D. S., Almansour, A. I., Perumal, K., & Nayaka, S. (2023). Unveiling the Pharmacological Significance of Marine Streptomyces violaceusniger KS20: Isolation, Characterization, and Assessment of Its Biomedical Applications. Metabolites, 13(9), 1022. https://doi.org/10.3390/metabo13091022










